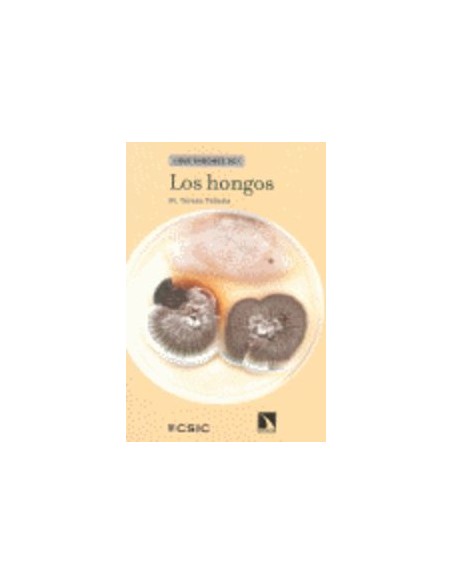
LOS HONGOS

Carrito
No hay más artículos en su carrito
LOS HONGOS
En los últimos años la micología ha experimentado un gran desarrollo: hoy se sabe que los hongos están emparentados con los animales, y no con las plantas;que no todos los organismos llamados hongos lo son;se vislumbra el papel crucial que desempeñan en
- paginas
- 128
- encuadernacion
- TAPA BLANDA O BOLSILLO
- espesor
- 8
- colección
- QUE SABEMOS DE
- altura
- 210
- ancho
- 140
1 Artículo
9788483195987
No hay comentarios